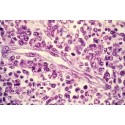

Panier
0
Produit
Produits
(vide)
Aucun produit
À définir
Livraison
0,00 €
Total
Produit ajouté au panier avec succès
Quantité
Total
Il y a 0 produits dans votre panier.
Il y a 1 produit dans votre panier.
Total produits
Frais de port
À définir
Total
Histoire des sciences
- NOUVEAUTÉS
- PODCAST DU MOIS
- PASS PHILO
- Arts, artistes, histoire de l'art
- Athéisme
- Civilisations
- Colloques
- Cycles de cours
-
Débats de société
- Afrique
- Bioéthique
- Culture et politique culturelle
- Démocraties
- Droits humains
- Ecole
- Espace & exploitation spatiale
- Europe
- Histoire - polémiques historiographiques
- Internet et réseaux sociaux
- Justice et système pénal
- Politique mondiale
- Politique française
- Santé publique
- Science
- Société
- Vieillesse & séniors
- Economie
- Ecologie
- Esprit critique
- Histoire
- Histoire Grèce Antique
-
Histoire de la philosophie
-
Histoire générale
- Les présocratiques
- Philosophie grecque
- Philosophie héllénistique
- Philosophie romaine
- Philosophie tardive
- Philosophie byzantine
- Philosophie islamique
- Philosophie médiévale
- Philosophie Renaissance
- Philosophie 17ème siècle
- Philosophie des Lumières
- Lumières européennes
- Lumières et judaïsme
- Philosophie 19ème siècle
- Philosophie 20ème siècle
- Philosophie 21ème siècle
- Courants philosophiques
- Philosophes
- Cycles philosophes
- Femmes et philosophie
-
Histoire générale
- Histoire de Révolutions
- Histoire des violences religieuses
- Journées d'étude
- Médecine
- Mythologies contemporaines
- Mots de la philosophie
- Qu'est-ce la PHILOSOPHIE ?
-
Philosophie - THÈMES
- Amour
- Animal
- Anthropocène
- Anthropogenèse
- Anthropologie
- Anti-connaissance, l'ignorantisme
- Art
- Autrui - Altérité
- Bonheur
- Condition historique
- Condition humaine
- Connaissance
- Connaissance de soi
- Conscience
- Corporalité et corporéité
- Cosmos
- Cosmosophia
- Crisologie
- Culture
- Démocratie
- Droits humains
- Écriture
- Epistémologie
- Epistémologie - Les voies de la connaissance
- Espace et aventure spatiale
- Place de l'Être humain dans la Nature
- Ethique
- Hasard, Aléas, contingence
- Humanisme
- Humanité
- Humanité - Odyssée culturelle
- Individu et individualisme
- Irrationalité et irrationalisme
- Justice
- Laïcité
- Liberté
- Mal
- Matérialisme
- Naturalité et naturel
- Nature humaine
- Politique
- Progrès
- Raison et rationalisme
- Réel et Réalisme
- Sectes et mouvements sectaires
- Société
- Sujetalité et sujet
- Thanatosophia
- Utopie
- Violence
- Vivant
- Voyage
- Polémiques philosophiques
-
Préjugés sexistes et de genre
- La révolution féminine
- Biologie, sexes et genres
- Contraception et avortement
- Discriminations féminines
- Ecole et inégalités de genre
- Féminismes
- Féminisme - Histoire
- Femmes pionnières
- Genre(s)
- Homophobies
- Journée internationale des droits des femmes
- Luttes féministes
- Masculinisme
- Misandrie
- Origines des sexismes
- Préjugés sexistes envers les femmes
- Santé des femmes
- Sexisme - état des lieux
- Sexualité
- Violences sexistes
- Religiologie
- SCIENCE - sur la science
- Science - Histoire des sciences
- Sciences humaines
- Sciences naturelles
- Sciences physiques
-
Sciences sociales
- Alimentation
- Communication et sémiologie
- Droit et histoire juridique
- Éducation
- Éthnologie
- Famille
- Fêtes
- Géographie et cartographie
- Géopolitique
- Immigration - Émigration
- Jeunesse et adolescents
- Jeux et ludisme
- Lien social
- Numérique, usages et pratiques
- Politologie
- Prospective
- Réseaux sociaux
- Rites funéraires et mort
- Santé sociale
- Société - thèmes divers
- Travail
- Urbanisme
- Sciences du vivant
- Technologies et techniques
-
Zététique
- Présentation de la zététique
- Histoire de la zététique
- Domaines de la zététique
- Méthodologie zététicienne
- Formations à la zététique
- Origine des croyances
- Anti-évolutionnisme
- Anti-rationalisme et obscurantisme
- Apocalyptisme(s)
- Archéomanie
- Astrologie
- Biais cognitifs
- Complotisme
- Croyances contemporaines
- Croyances corporelles
- Croyances écologistes
- Croyances pseudo-scientifiques
- Croyances spatiales, OVNI, ET...
- Développement personnel
- Esotérisme
- Fake news
- Médias et réseaux sociaux
- New Age et néospiritualités
- Parapsychologie
- Pseudo-sciences
- Pseudo-médecines et pseudo-thérapies
- Revisionnisme historique
- Surnaturel
- Technophobie et scientophobie